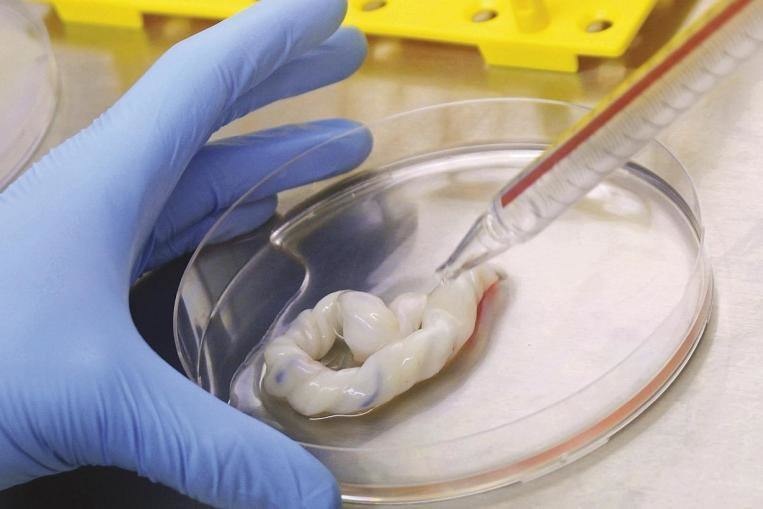
Clinical Research

Ärzte erklärten dieses Baby ein Wunder, nachdem er das Nabelschnur bemerkte
Social Media-Plattform ist ein Ort, an dem die Menschen verschiedene Dinge tun können. Sie können alles posten, was sie wollen. Sie können sich anschließen, wann immer sie können. Es ist zu einem IMPO geworden
Social Media-Plattform ist ein Ort, an dem die Menschen verschiedene Dinge tun können. Sie können alles posten, was sie wollen. Sie können sich anschließen, wann immer sie können. Es ist zu einem wichtigen Teil des täglichen Lebens der Menschen geworden. In dieser Geschichte spielte eine Social-Media-Plattform, reddit, eine entscheidende Rolle.
Eine interessante Plattform

Reddit ist wirklich gut, wenn Sie im Internet für faszinierende Geschichten surfen. Viele Leute besuchen jeden Tag reddit. Sie teilen ihre Erfahrungen mit der Welt. Reddit hat sogar Unterkategorien, in denen Sie ein bestimmtes Thema nachschlagen und seine vollständigen Informationen lesen können. Es gibt mehrere Themen, die darauf verfügbar sind. Diese unglaubliche Geschichte ist von einem solchen Thema.
Platz für das Teilen von persönlichen Erlebnissen

Eine der am meisten besuchten Kategorien auf Reddit ist die "Bilder". In "Pics" -Kategorie teilen sich die Kategorie Persönlichkeiten, die Bilder von faszinierenden Dingen teilen oder sogar Erfahrungen durch Beschriftung der Fotografien zeigen. Azathothfrog ist ein RedDitor, der 2015 ein erstaunliches Foto hochgeladen hat und das Wunder beschrieb, das die Geburt seines Sohnes war.
Die gemeinsamen Komplikationen

Ein Frauenkörper ist biologisch dazu gedacht, mit jemandem ein Geschenk des Lebens zu tragen und zu geben. Und während dieses Prozesses können Probleme jederzeit auftreten. Die Komplikationen während der Schwangerschaft sind sehr häufig. Es ist sehr häufig, insbesondere in unterentwickelten Ländern. Eine der Hauptursachen dieses Problems ist das Nabelschnur.
Wichtigkeit der Nabelschnur

Die Hauptfunktion der Nabelschnur besteht darin, während ihrer Entwicklungszeit Nährstoffe und Sauerstoff von der Mutter an das Baby zu liefern. Die Dinge können jedoch schlechter werden, wenn die Nabelschnur an der falschen Stelle endet.
Die Schwangerschaftsphase war glatt

Die Schwangerschaftsphase der Frau von Azathothfrog war glatt. Glücklicherweise leidete ihr Körper nicht an verschiedenen Infektionen oder ernsthaften Komplikationen. Das Paar machte vor der Ankunft ihres Kindes spezielle Arrangements. Aber sie wurden nie vorbereitet, was als nächstes passiert ist.
Liefertag

Am Liefertag ging alles nach dem Plan. Seine Frau wurde nach einigen Stunden Arbeit in den Lieferraum verschoben. Azathothfrog war mit ihrer ganzen Zeit mit ihr. Nach einer Weile begann der Kopf des Babys zu krönen.
Das fantastische Gefühl

Azathothfrog hat die Ankunft seines neugeborenen Babys erlebt. Er war völlig ehrfürchtig. Er fühlte sich wirklich unwirklich, als er den ersten Schrei des Kindes hörte. Nach der Reinigung des Babys entdeckten die Ärzte etwas auf dem Körper seines Babys, was ihn betäubt hat.
Selten von seltenen Fällen

Als die Ärzte die Nabelschnur loswerden, beobachteten sie, dass es in einem perfekten Knoten gebunden war! Es bedeutete, dass das Blut nicht richtig auf das Baby floss oder Abfall beseitigt wurde, und dies könnte zum Tod führen. Im Gegensatz zu anderen Fällen atmete dieses Baby normal, weinte, und seine Haut war die normale Farbe. Er war perfekt! Nach Angaben der Ärzte war dies der seltene seltene Fälle. In Anbetracht dessen, dass sie dem Vater diesen Moment aufgenommen haben.
Eine Wunder-Geburt.

"Beeilen Sie sich, Papa, machen Sie ein Foto, Ihr Baby ist ein Wunder", schrie einer der Ärzte in Azathothfrog. Und natürlich tat es natürlich. Er teilte das Bild seines Babys auf reddit. Eine Fülle von Menschen kommentierte seinen Posten und teilten ihre eigenen Geschichten. Sie waren einfach erstaunt. Einer der Geschichten packte jedoch alle Augäpfel von allen.
Eine glückliche Familie

Der RedDitor schrieb, dass er als Anästhesist arbeitete und über 15 Jahre Erfahrung in den Liefer- und Betriebs-Theatern hatte. Er gratulierte Azathothfrog und sagte ihm dann, dass seine Familie wirklich Glück hatte. Er zeigte weiter, dass er während seiner Karriere eine Fülle von wundersamen Sachen erlebt hatte, aber eines der traurigsten Fälle haftete nur mit der Nabelschnur.
Zunächst war alles perfekt!

Eine schwangere Frau wollte einen C-Sektionsbetrieb für die Geburt ihres Babys haben. Nur einen Tag vor der Operation ging die Frau, um ihren Arzt zu sehen, nur um sicherzustellen, dass alles gut war. Alles schien einfach gut zu sein, und ihr Arzt sagte ihr, sie solle sich entspannen und nach Hause gehen. Am nächsten Tag, als die Frau im Krankenhaus ankam, wurde sie über die schmerzlichen Nachrichten informiert.
Ein tragischer Verlust

Die Frau war alles auf die Operation vorbereitet. Als sie den letzten Ultraschall unternahm, zeigte das Baby keine Bewegung, und es gab auch keine Anzeichen von Herzschlägen. Später erkannten die Ärzte, dass die Nabelschnur geknotete, die den Tod des Babys verursachte.
Whartons Gelee

Verwicklungen und Schlaufen sind in der Nabelschnur ziemlich üblich. Wie in den Daten befinden sich jedoch nur 1% der Kabel, die tatsächliche Knoten in ihnen haben, was den Blutfluss verhindert. In den meisten Fällen enthalten Nabelschnüre eine Schleimsubstanz in ihnen, die als Whartons Gelee genannt wird, der die Blutgefäße vor dem Komprimieren schützt.
Eine natürliche Klammer

Während der Geburt ist die Außentemperatur im Vergleich zum Mutterleib des Mommy vielkühlt. Wenn das Kabel der kühleren Luft ausgesetzt ist, drückt das Wharton-Geleekompressen, er dreht sich hart, was dazu führt, dass ein Quetschen und Schalung des Blutgefäßes führt. Aufgrund dessen klemmt das Kabel natürlich vor, bevor ein Arzt ihn schneiden kann. Aber das ließ es nicht nutzlos.
Die Forschung ist eingeschaltet!
Klinisch besitzen Nabelschnüre diese Zellen, die in der Lage sind, verschiedene Zellenarten zu regenerieren und zu erstellen. Diese Zellen sind effizient genug, so dass sie Knochen, Knorpel, Muskeln und Fett herstellen können. Weitere Forschungen sehen an, wie es verwendet werden kann, um Bedingungen wie Multipler Sklerose, Zerebralparese, Parkinson-Krankheit und rheumatoide Arthritis zu behandeln.
16 Mädchen aus den 90er Jahren hatten alle einen Schwarm
6 Interessante Fakten über den Chefkoch Renatta Moeloek, schöne Jury Masterchef Indonesien